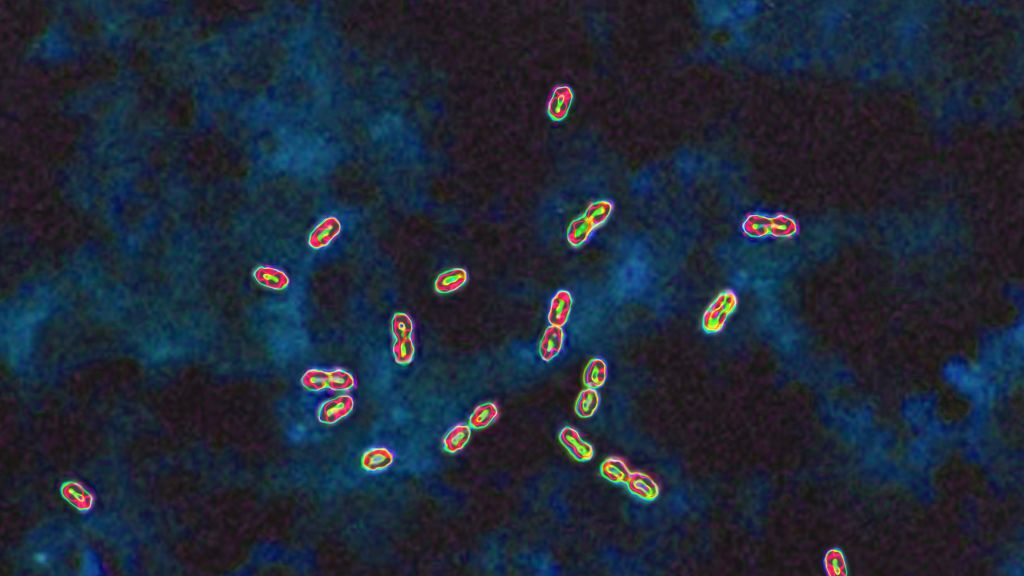

Se calcula que entre 1918 y 1920, la llamada «gripe española» causó entre 20 y 100 millones de muertos en todo el mundo, convirtiéndose en una de las pandemias más devastadoras de la historia. Pero, ¿qué mutaciones permitieron al virus de la gripe A H1N1 adaptarse a los humanos y, sobre todo, volverse tan virulento? Un equipo de investigadores de las universidades de Basilea y Zúrich, en colaboración con otras universidades, intentó responder a esta pregunta analizando muestras conservadas en formol y custodiadas en el Instituto de Medicina Evolutiva de la Universidad de Zúrich. Uno de los ejemplares fue especialmente clave: se trataba de un tejido pulmonar perteneciente a un joven de 18 años fallecido en 1918, durante la primera oleada de la pandemia en Suiza.
Extracción de ARN viral de muestras con 100 años de antigüedad
En el estudio, publicado en BMC Biology, el equipo de investigadores desarrolló una nueva técnica para extraer el material genético del virus de muestras conservadas en formol. «Las colecciones médicas son un archivo inestimable para la reconstrucción de antiguos genomas virales de ácido ribonucleico (ARN)», explica Frank Rühli, coautor del estudio y director del Instituto de Medicina Evolutiva de la Universidad de Zúrich. Sin embargo, el potencial de estas muestras sigue estando desaprovechado.
El ARN es mucho menos estable que el ADN y solo se conserva a largo plazo en condiciones muy específicas, añade el primer autor, Christian Urban. Al mismo tiempo, estudiar cómo se adaptan los virus durante una pandemia puede aportar información valiosa paramodelizar el curso de cualquier ola futura. «Por eso hemos desarrollado un nuevo método para mejorar nuestra capacidad de recuperar fragmentos antiguos de ARN a partir de esas muestras», prosigue Urban.
Tres mutaciones clave
Los análisis, y las comparaciones con los escasos genomas del virus de la gripe española publicados previamente a partir de estudios en Alemania y Norteamérica, mostraron que la cepa que circulaba en Suiza presentaba tres mutaciones clave en 1918, que se conservarían dentro del genoma viral hasta el final de la pandemia.
Dos de estas mutaciones habrían hecho al virus de la gripe española más resistente a un factor antiviral del sistema inmunitario humano, considerado una importante barrera contra la transmisión de los virus de la gripe aviar de animales a humanos. La tercera mutación se refiere a una proteína de la membrana del virus que mejoraría su capacidad para unirse a receptores específicos de las células humanas, lo que haría al virus más resistente y más contagioso.
«Es la primera vez que tenemos acceso al genoma de un virus de la gripe relacionado con la pandemia de 1918-1920 en Suiza», concluye Verena Schünemann, una de las autoras principales de la investigación, paleogenetista y profesora de ciencias arqueológicas en la Universidad de Basilea. «Esto nos da nueva información sobre la dinámica de adaptación del virus en Europa al principio de la pandemia».
Artículo originalmente publicado en WIRED Italia. Adaptado por Alondra Flores.